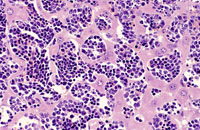
erythroleukemia

The Digitized Atlas of Mouse Liver Lesions

Much of the work carried out by DTT is in support of the National Toxicology Program (NTP), an interagency partnership of the Food and Drug Administration, National Institute for Occupational Safety and Health, and NIEHS.
Visit the NTP WebsiteErythroleukemia is a spontaneous hematopoietic neoplasm of Tg.AC mice characterized by marked hepatomegaly. The affected liver is infiltrated by metarubricytes and less differentiated erythroid precursors.
Low magnification of erythroleukemic infiltrates in the liver.
A higher magnification of hepatic erythroleukemia.
Examples of erythroleukemia in a Tg.AC mouse.